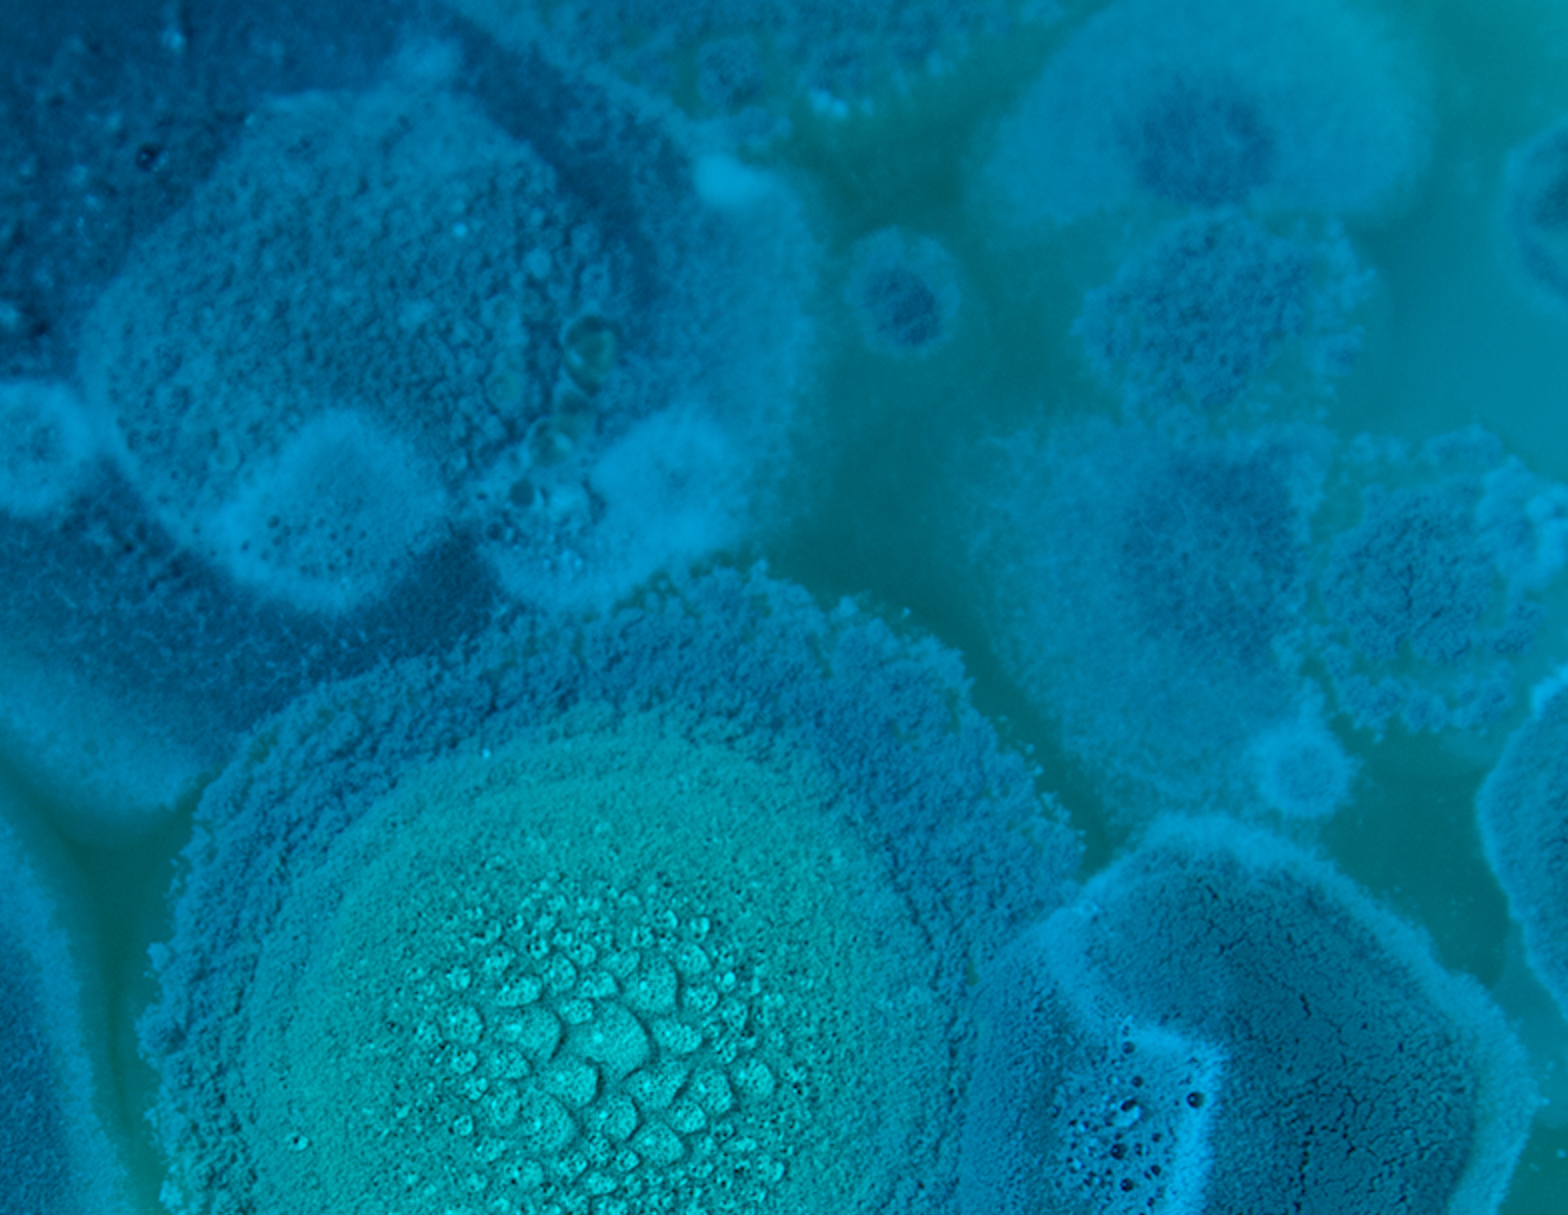

Wir bringen eure Themen in Bewegung.
Viele Kommunen, Organisationen und Stiftungen wollen komplexe Themen in Gang setzen, die über sie selbst hinaus wachsen sollen. Dafür braucht es lebendige Netzwerke und die Expertise, sie wachsen zu lassen.
Uns kennenlernen
Jeden Freitag Offene Tür ->
Die Anlaufstelle für Wandel, der bewegt.
Wir glauben: Es geht nur gemeinsam.
Oder etwas theoretischer ausgedrückt: Um der Komplexität im Außen zu begegnen, braucht ein System die entsprechende Komplexität auch im Innen. Sprich, es braucht viele unterschiedliche Perspektiven, Fähigkeiten, Erfahrungen und Hintergründe. Die gilt es zusammenzubringen, so dass das ganze System lernen kann.
Das machen wir konkret, indem wir Communities und lebendigen Netzwerken beim Wachsen helfen, Konferenzen gestalten und moderieren, Transformationsprozesse begleiten und unser Wissen und unsere Expertise in diesen Bereichen in unseren Ausbildungen weitergeben.
Warum
Emergenz?
Emergenz bezeichnet das Entstehen neuer Strukturen, Eigenschaften und Zustände aus dem Zusammenspiel verschiedener Akteure, wobei das, was entsteht noch mal ganz neue Eigenschaften hat – das Ganze ist also mehr als nur die Summe seiner Teile.
Zu abstrakt? So erklärt Nora Bateson Emergenz,
so Margaret Wheatley, und hier geht es zu einem kurzen Erklärvideo zu Emergenz.
Was wir
konkret tun
Wir sind erfahrene Partner, wenn es um lebendige Netzwerke geht. Wir helfen dabei, Netzwerke zu initiieren, die Kommunikation zu etablieren, Zusammenkünfte zu gestalten, kluge Strukturen für den Wissenstransfer aufzubauen und auch sonst bei allen strategischen Fragen im Kontext lebendiger Netzwerke zu unterstützen.
Wir zeigen in unseren Ausbildungen und Seminaren, wie man lebendige Netzwerke in oder über Organisationen hinweg wachsen lässt, dafür gibt es nämlich ganz bestimmte Schritte, die befolgt und Fähigkeiten, die erlernt werden wollen. Als langjähriger Unterstützer der Inner Development Goals bieten wir Impuls-Workshops zu den IDGs. Unsere Vortrags- und Moderationsthemen reichen von Emergenz über Bau lebendiger Netzwerke bis hin zu Futures Literacy und den Umgang mit Ungewissheit.

Der Zweite Kreis
- oder wie sich Transformationsenergie freisetzen lässt.
Viele Organisationen, Institutionen und Kommunen stehen vor ähnlichen Fragen:
- Wie gelingt Veränderung, ohne alles zentral zu steuern?
- Wie werden Menschen aktiviert, die bereits engagiert und gut vernetzt sind sowie andere mitziehen können? Und damit unterstützen und entlasten können?
- Wie entsteht daraus vielleicht sogar eine Bewegung?
Das Konzept des zweiten Kreises ist einen Ansatz, um freiwilliges Engagement, bestehende Verbindungen und vorhandenes Wissen gezielt zu bündeln – ohne formale Beteiligungsprogramme oder klassische Projektlogiken.
Der zweite Kreis schafft einen Raum zwischen Kernteam und Gesamtorganisation, in dem Menschen:
-
Veränderung mittragen und mit umsetzen
-
Themen multiplizieren und sichtbar machen
-
Informationen aus unterschiedlichen Teilen des Systems einbringen
-
Bewegung ermöglichen, ohne Steuerung oder Mandat
In einem kostenlosen Online-Impuls stellen wir das Konzept des Zweiten Kreises vor: ein Ansatz, bei dem freiwilliges Engagement, bestehende Verbindungen und vorhandenes Wissen gezielt gebündelt wird – ohne formale Beteiligungsprogramme oder klassische Projektlogiken.
Lebendige Netzwerke
Vom Aufbau bis hin zur Gestaltung und Durchführung
innovativer Konferenzformate
...es muss gar nicht gleich so groß sein, schon eine klug gestaltete Veranstaltung wie z.B. eine Konferenz kann sofort Wissen freilegen, Menschen vernetzen und so den Boden für Wandel bereiten.
Deshalb geben wir uns auch nicht mit der Präsentation von Keynotes zufrieden, sondern setzen damit lediglich Impulse, die dann direkt im Anschluss von den Teilnehmenden in von uns moderierten Formaten weiterentwickelt und zurück in die Teams getragen werden.
Uns Kennenlernen
Wir sind hier, um Sie zu unterstützen.
Das Institut für praktische Emergenz ist außerdem Entwicklungspartner für Themen wie Futures Literacy,
Nachhaltigkeit in Organisationen, Inner Development Goals und einige mehr.
Mehr Infos gibt's hier oder noch besser, kontaktieren Sie uns bzw. kommen Sie doch gleich mal bei uns in München auf einen Kaffee / Tee vorbei!

Ausbildung:
Lebendige Netzwerke
In dieser 6-wöchigen, hybriden Ausbildung dreht sich alles um lebendige Netzwerke. Was unterscheidet sie von Netzwerken, wie wir sie kennen?
Warum brauchen wir sie heute sogar dringender denn je?
Lebendige Netzwerke lassen sich nicht bauen im klassischen Sinn, aber man kann ihnen beim Wachsen helfen.
Dafür braucht es solides Handwerkszeug: Experience Design, die Grundlagen des Community Weaving, Konfliktbewältigung, Moderationsskills, Gruppendynamik und vieles mehr werden in dieser fundierten Ausbildung vermittelt und eingeübt.

Impuls Workshop:
Inner Development Goals
Wir fördern seit 2021 die Verbreitung der IDGs und unterstützen Organisationen gerne dabei, das Thema bei sich vorzustellen.
In diesem 4-stündigen Impuls-Workshop geben wir einen Überblick über die Inner Development Goals und deren Relevanz gerade im aktuellen Kontext und erarbeiten gemeinsam, was das konkret für Ihre Organisation und Ihre Mitarbeiter:innen bedeutet.
Wir identifizieren Entwicklungsmöglichkeiten
(z. B. durch ein Assessment) und definieren, was die nächsten Schritte wären.
Die Menschen dahinter:
Das Institut für praktische Emergenz stellt sich vor!

Rike Pätzold, M.A.
Rike Pätzold berät, schreibt, lehrt und beschäftigt sich
leidenschaftlich mit Emergenz, partizipativer Zukunftsgestaltung und
damit, wie sich gut mit Ungewissheit und Komplexität umgehen lässt.
Im Rahmen des IPEs erforscht sie neue Wege, lebendige Systeme von innen
heraus zu verändern und erprobt sie in ihrer praktischen Arbeit als
Beraterin für Organisationsentwicklung.
Rike ist gebürtige Münchnerin, wo sie nun wieder mit ihrer
Patchwork-Familie lebt, nachdem sie den Nordatlantik auf einem Segelboot
umrundet hat. Rike hat Sinologie, Japanologie und Sprachphilosophie
studiert und mehrere Jahre in Taiwan gelebt, um ihre Kenntnisse des
Chinesischen und des Daoismus zu vertiefen.

Lena Tünkers
Lena Tünkers beschäftigt sich mit der Frage, wie Menschen und Organisationen mit unvorhersehbaren Zukünften umgehen können – und wie in solchen Situationen neue Möglichkeiten entstehen. In ihrer Arbeit verbindet sie strategisches Denken aus ihrem Hintergrund in Innovation und Futures Studies mit einer künstlerischen Sensibilität, die aus ihrer Leidenschaft für Musik und Tanz gewachsen ist. Zugleich prägen Experimentierfreude und eine pragmatische Macher-Mentalität ihre Herangehensweise.
Lena ist in Düsseldorf geboren und lebt heute in Zürich. Sie hat bereits auf mehreren Kontinenten gelebt, was ihre
Neugier auf Menschen, Kulturen und das Unbekannte nachhaltig geprägt hat.

Vanessa Ludewigs
Vanessa Ludewigs interessiert der Aufbau von Netzwerken - Menschen zusammenzubringen, die gemeinsam Neues gestalten können. In ihrer Arbeit beschäftigt sie sich damit, wie sich Systeme und Organisationen neu denken lassen. Besonders Gruppen und wie sie zusammenarbeiten, faszinieren sie, und die Frage, wie sie sich unterstützen lassen. Vanessa ist ausgebildete Industriekauffrau, und hat einen MBA in Change-Management und viele Jahre Erfahrung in der klassischen Unternehmensberatung. Dabei waren Change und Transformation schon immer ihre Steckenpferde. Gemeinsam mit Kerstin Gollner leitet sie EQU:WIN und liebt es, anspruchsvolle und komplexe Projekte anzugehen, umzusetzen und zu leiten.

Dr. Kerstin Gollner
Kerstin Gollners Passion sind Veränderungsmanagement,
Organisationsentwicklung und Transformationsprozesse. In diesem Feld
arbeitet sie seit 30 Jahren und begleitet große und komplexe
Veränderungen in Unternehmen.
Als Geschäftsführerin von EQU:WIN stellt sie heute ihre Erfahrung in den
Dienst von Organisationen, Städten und Kommunen, um diejenigen
Veränderungsdynamiken anzustoßen, die notwendig sind, um mit den großen
gesellschaftlichen Herausforderungen unserer Zeit fertig zu werden. Mit
dem Thema Emergenz und soziale Dynamiken beschäftigt sie sich seit dem
Studium. Kerstin Gollner hat einen PhD in Ökologischer Ökonomie. Sie
lebt mit ihrer Familie in der Nähe von München.
Uns kennenlernen
Jeden Freitag
Offene Tür ->
Vernetzung & Austausch
Für Emergenz braucht es vernetzte Strukturen. Wir werden nicht müde, Ideen, Menschen, Initiativen und Ideen zu finden, sie vorzustellen und zusammenzubringen, damit tragende Gemeinschaften und Netzwerke entstehen und sich Ideen fortpflanzen können.
Mit Ideen vernetzen:
Die Ressourcenliste
Was es alles schon gibt: eine laufend
wachsende, vielfältige und internationale Sammlung spannender und inspirierender Initiativen und Ideen, die sich mit gesellschaftlichem Wandel, Zukünften, spekulativem Design usw. beschäftigen.
Mit anderen vernetzen: Veranstaltungen
Nehmen Sie an einer
unserer Veranstaltungen teil, z.B. die Online-
Impulse zu neuen Themen (KI, IDGs,
Futures Literacy...): Neues entdecken, sich
inspirieren lassen und eigene Erfahrungen
einbringen. Vor allem mit
anderen vernetzen und austauschen.
Mit uns vernetzen:
Open Door
Unsere Arbeit interessiert Sie? Sie würden uns gerne kennenlernen bzw. sich einfach mit uns austauschen? Wir freuen uns und
laden Sie ein zu unserem Open Door
freitags zwischen 10:00 und 12:00. Einfach
hier auf den Link klicken und Termin
vereinbaren.
Unser Podcast Factor Em
Lernen über Emergenz von Praktiker:innen und Expert:innen
Wie kommt das Neue in die Welt? Das wollen wir wissen, und zwar von denjenigen, die täglich mit Veränderungsprozessen zu tun haben, von Praktiker:innen und Expert:innen. Was können sie uns aus ihrer Erfahrung mitgeben? Was sollten wir verstehen zu Themen wie
Risiko und Emergenz? Warum sind Dringlichkeit und Geschwindigkeit nicht der richtige Ansatz, um komplexe Herausforderungen zu lösen?
Welche Rolle spielt Vernetzung für Innovation und Transformation? Und was hat es auf sich mit glücklichen Zufällen?
Tanja Gronde vom Bayerischen Rundfunk und Rike Pätzold holen sich von ihren Gäst:innen außer spannenden Antworten und Impulsen außerdem Hausaufgaben, um gleich selbst ins Experimentieren zu kommen. Und die Hörer:innen sind herzlich eingeladen, mitzumachen.

Das IPE unterstützt seit 2021 die
Inner Development Goals
und hostet den IDG Munich Community Hub gemeinsam mit einem tollen Kernteam. Interesse an den IDGs und im Münchner Raum daheim oder unterwegs? Dann gerne unverbindlich bei uns in
Howspace
vorbeischauen und fürs nächste Hub-Treffen anmelden.

Die
Design Futures Initiative
bringt Designer, Strategen, Ingenieur:innen, Wissenschaftler:innen, Künstler:innen und Futurist:innen aus der ganzen Welt zusammen. Das IPE ist offizieller Partner der Initiative und hostet das Münchner Chapter
. Interesse mitzumachen oder einfach mal vorbeizukommen? Einfach uns anschreiben!
Hier sind wir involviert:
NxF | navigate by fiction.
Die Methode für partizipative Zukunftsgestaltung in Städten und Gemeinden sowie in Organisationen bringt Menschen zusammen und richtet sie auf eine gemeinsam erzählte Zukunft hin aus.
Gemeinsam. Zukunft. Machen.
Eine neuartige Form der Bürgerbeteiligung in Kooperation mit engagierten
Einwohner*innen einer Gemeinde auf Basis unserer
Zukunftsgestaltungsmethode NxF.
Bibliothek der Zukünfte
Stöbern Sie in der ständig wachsenden Bibliothek der Zukünfte, in der
wir die durch unsere partizipative Zukunftsgestaltungsmethode NxF
entstandenen Zukunftsgeschichten sammeln.
EQU:WIN Consulting
Die Beratung für Transformation behandelt Organisationen als lebendige Organismen und
sieht gelingende Beziehungen und Kooperation als
Voraussetzungen für Veränderung.
